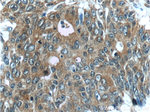
FERMT1 Antibody in Immunohistochemistry (Paraffin) (IHC (P))

Search
Proteintech
FERMT1 Polyclonal Antibody
{{$productOrderCtrl.translations['antibody.pdp.commerceCard.promotion.promotions']}}
{{$productOrderCtrl.translations['antibody.pdp.commerceCard.promotion.viewpromo']}}
{{$productOrderCtrl.translations['antibody.pdp.commerceCard.promotion.promocode']}}: {{promo.promoCode}} {{promo.promoTitle}} {{promo.promoDescription}}. {{$productOrderCtrl.translations['antibody.pdp.commerceCard.promotion.learnmore']}}
产品信息
22215-1-AP
种属反应
已发表种属
宿主/亚型
分类
类型
抗原
偶联物
形式
浓度
规格
纯化类型
保存液
内含物
保存条件
运输条件
产品详细信息
Immunogen sequence: HISKLSLSA ETQDFAGESE VDEIEAALSN LEVTLEGGKA DSLLEDITDI PKLADNLKLF RPKKLLPKAF KQYWFIFKDT SIAYFKNKEL EQGEPLEKLN L (321-420 aa encoded by BC035882)
靶标信息
Kindlin 1 is a member of the kindlin family of focal adhesion proteins and contains a FERM domain and pleckstrin homology domain. It is involved in integrin signaling, linkage of the cytoskeleton to the extracellular matrix, and cell adhesion. It is most often expressed in epithelial cells. When kindlin 1 is coexpressed with talin it helps to activate ITGA2B. It is required for keratinocyte proliferation, polarization of basal keratinocytes in the skin, and for normal cell shape. Mutations in kindlin 1 have been linked to Kindler syndrome, a recessive skin disorder involving blistering, photosensitivity, poikiloderma, and atrophy.
仅用于科研。不用于诊断过程。未经明确授权不得转售。
生物信息学
蛋白别名: Fermitin family homolog 1; fermitin family member 1; FLJ20116; FLJ23423; Kindlerin; kindlin 1; Kindlin syndrome protein; Kindlin-1; RP5-1056H1.1; similar to Caenorhabditis elegans Unc-112 related protein 1; Unc-112-related protein 1; UNC112 related protein 1; unnamed protein product
基因别名: 5830467P10Rik; C20orf42; DTGCU2; FERMT1; KIND1; Kindlin-1; UNC112A; URP1
UniProt ID: (Human) Q9BQL6, (Mouse) P59113
Entrez Gene ID: (Human) 55612, (Mouse) 241639